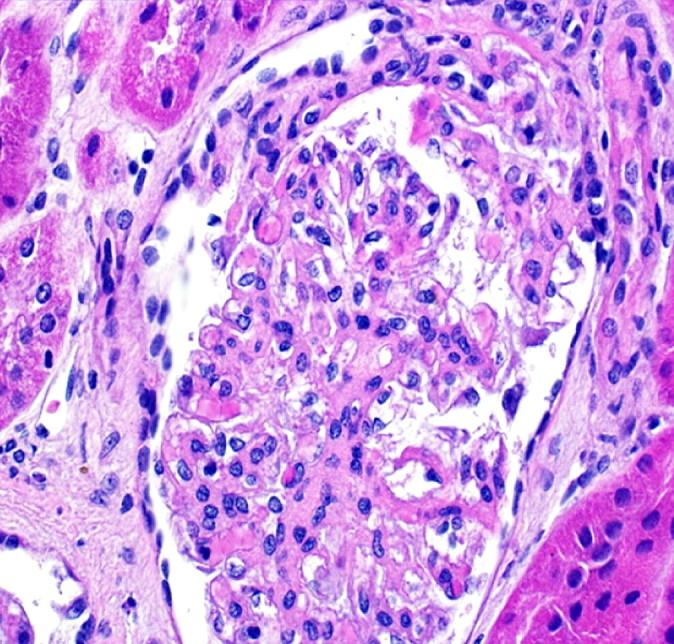
https://cdn.ncbi.nlm.nih.gov/pmc/blobs/7606/4421729/a05f63fac498/ndtplussfr054f02_3c.jpg

Falling through the cracks of vasculitis classification-a report of three patients.
作者信息
Havill John P, Levine Stuart M, Kuperman Michael, Hellmann David B, Geetha Duvuru
机构信息
Division of Nephrology, Department of Medicine, Johns Hopkins Bayview Medical Center, Baltimore, MD, USA.
Division of Rheumatology, Department of Medicine, Johns Hopkins Bayview Medical Center, Baltimore, MD, USA.
出版信息
NDT Plus. 2011 Oct;4(5):327-30. doi: 10.1093/ndtplus/sfr054. Epub 2011 Apr 14.
Abstract
摘要